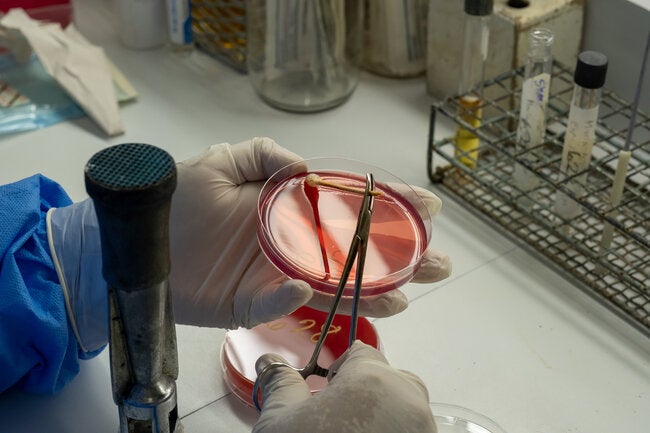
Resistencia Antimicrobiana

La Organización Panamericana de la Salud/Organización Mundial de la Salud (OPS/OMS) en El Salvador se complace en compartir los destacados logros alcanzados en colaboración con el país, resaltando ocho áreas clave que reflejan un avance significativo en la mejora de la salud pública, basados en la Estrategia de Atención Primaria de la Salud Renovada.
1. Control de la pandemia de COVID-19:
Con una cooperación técnica sólida y estratégica, El Salvador ha alcanzado un hito importante en el control de la pandemia de la COVID-19. Esto se ha logrado mediante la implementación efectiva de la vigilancia epidemiológica y genómica, la realización de pruebas en redes de laboratorios de salud pública y la intensiva aplicación de vacunas contra el SARs-COV-2.
2. Consolidación del Sistema Nacional Integrado de Salud (SNIS):
El país ha consolidado un SNIS más resiliente, evaluando y desarrollando las Funciones Esenciales de Salud Pública, fortaleciendo programas prioritarios y asegurando un financiamiento público adecuado.
3. Uso intensivo del Campus Virtual de Salud Pública (CVSP):
El incremento notable en el uso del CVSP refleja un compromiso continuo con el desarrollo profesional y la promoción de la salud, destacando experiencias exitosas en cursos sobre Funciones Esenciales de Salud Pública y HEARTS plus.
Resaltamos:
Existe un notable incremento del uso del nodo Regional por parte de El Salvador. Ha pasado de poco más de 2 mil participantes en 2019 a 49,700 participantes en 2023, se han matriculado 77,128 personas a diversos cursos y se han logrado 51, 021 certificaciones.
5. Implementación del Plan Nacional contra la Resistencia Antimicrobiana (RAM):
El Salvador ha implementado con éxito su Plan Nacional contra la RAM, fortaleciendo la capacidad técnica e incorporando estrategias recomendadas por la OPS/OMS.
Resaltamos:
Se adoptó la clasificación AWaRe de antibióticos de la OMS en el Listado Institucional de Medicamentos Esenciales de El Salvador, publicado en coordinación con la Dirección Nacional de Medicamentos.
6. Implementación integral de la Iniciativa HEARTS:
Se ha logrado la implementación rápida y completa de la Iniciativa HEARTS en todo el Sistema Nacional Integrado de Salud, abordando la hipertensión arterial y la enfermedad cardiovascular.
Resaltamos:
- El 100% de los establecimientos de atención primaria de salud (764) se encuentran implementando la iniciativa.
- Son alrededor de 8,000 profesionales de salud capacitados (médicos, enfermeras y promotores de salud).
-El 100% de los centros cuenta con dispositivos electrónicos validados, asimismo, el 100% de las unidades de atención de primaria cuentan con la plataforma electrónica de monitoreo y evaluación de HEARTS.
-Los resultados demuestran un control de la presión arterial en el 81.3 % de los hipertensos de bajo riesgo y el 63.2% de los hipertensos con alto riesgo cardiovascular.
7. Reducción de tasa de mortalidad de Cáncer Cervicouterino:
El sistema de salud de El Salvador ha implementado estrategias para brindar la mejor atención entorno al VPH y reducción de la tasa de mortalidad del cáncer cervicouterino.
Resaltamos:
-Se amplió la cobertura de vacunación, incorporando la vacuna contra VPH en el esquema nacional de vacunación para niños y niñas de 9 y 10 años. El 100% de las unidades de salud cuenta con el tamizaje de la prueba de VPH para lo cual se cuenta con 19 laboratorios de procesamiento.
-Se ha capacitado a más de 5000 profesionales de salud multidisciplinarios en el abordaje integral del cáncer cervicouterino.
8. Profundización de la aplicación del Convenio Marco del Control del Tabaco (CMCT):
Mediante la campaña “Denuncia la Publicidad Tóxica”, se ha fortalecido la prohibición de la publicidad, promoción y patrocinio del tabaco.
Resaltamos:
La campaña sobre el control del tabaco aborda los factores sociales que influyen en la salud, promoviendo un entorno libre de tabaco para todos los salvadoreños, se alcanzaron 800,000 usuarios de diferentes entre redes sociales y publicidad en principales vías del país.
Estos logros reflejan el compromiso continuo de El Salvador y la OPS/OMS en mejorar la salud de la población a través de enfoques holísticos y sostenibles, basados en la Estrategia de Atención Primaria de la Salud Renovada.